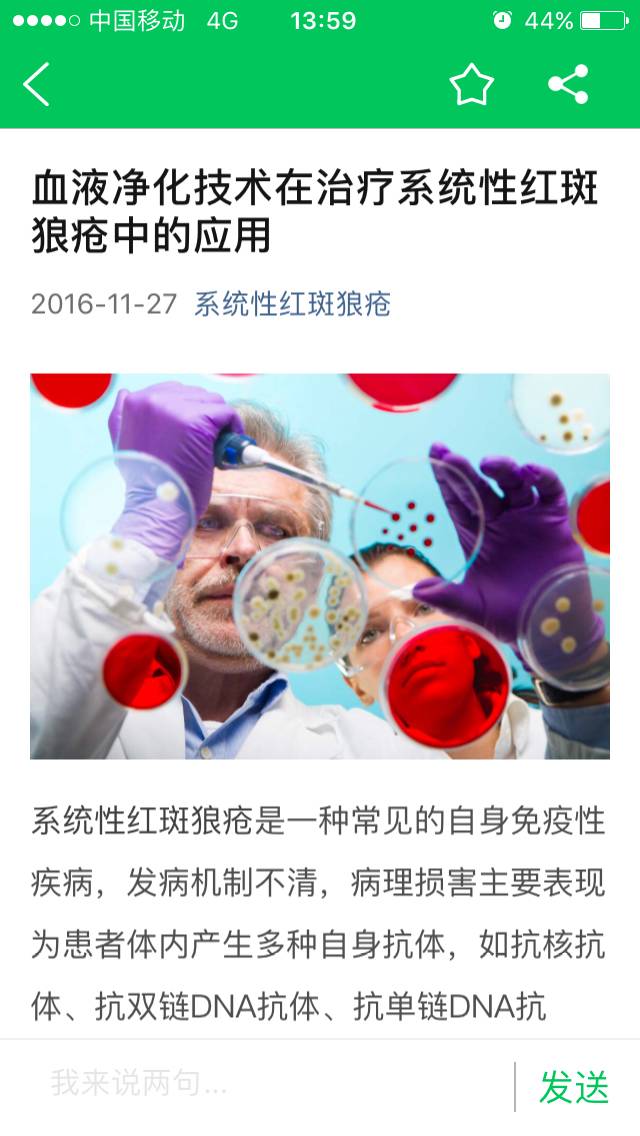

参与评论
评论列表
按投票顺序
我刚做了
举报
2016-11-27 16:09:59 有用(2)
回复(2)
这个钱要花挺多的
举报
2016-11-27 16:21:43 有用(1)
回复(2)
我做过,抗核抗体低度高的时候重症狼疮建议做,其它的做了效果不明显
举报
2016-11-27 14:07:25 有用(1)
回复(3)
在我们病情活动期可以起到关键作用,用了之后可以快速的控制病情和减少对人体其它的伤害。
举报
2016-11-27 14:12:05 有用(1)
回复(3)
这个是适合重症人用的,而且还是得配合激素,纷乐
举报
2016-11-27 14:23:34 有用(1)
回复(0)
来学习
举报
2016-11-27 18:00:21 有用(1)
回复(0)
看些图
举报
2016-11-27 15:12:49 有用(1)
回复(0)
我得病不是很重,发现的早,我做免疫吸附了,不能治愈,因为做的价位高,医生说可以做可以不做,做了身体好的快些,我激素减的挺快,也许是做免疫吸附的作用吧
举报
2016-11-27 15:19:07 有用(1)
回复(0)
觅健平台里的帖子
举报
2016-11-27 14:01:46 有用(0)
回复(0)
费用高,好像效果还不持久
举报
2016-11-27 19:02:12 有用(0)
回复(0)
谢谢亲们回复,知道了
举报
2016-11-27 18:10:13 有用(0)
回复(0)
相关推荐
热点推荐
暂无数据






